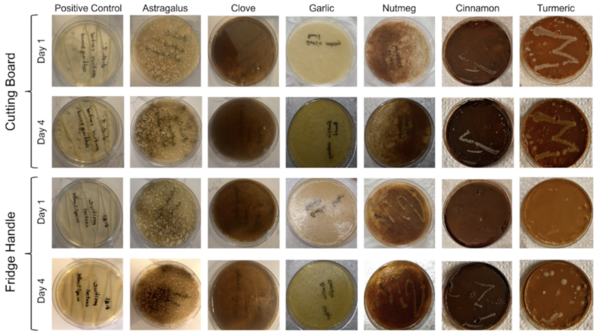
Antimicrobial properties of common household spices on microbes cultured from two kitchen locations

Aquaponics (the combination of aquatic plant farming with fish production) is an innovative farming practice, but the fish that are typically used, like tilapia, are expensive and space-consuming to cultivate. Medina and Alvarez explore other options test if mosquitofish are a viable option in the aquaponic cultivation of herbs and microgreens.
Read More...
.jpeg)